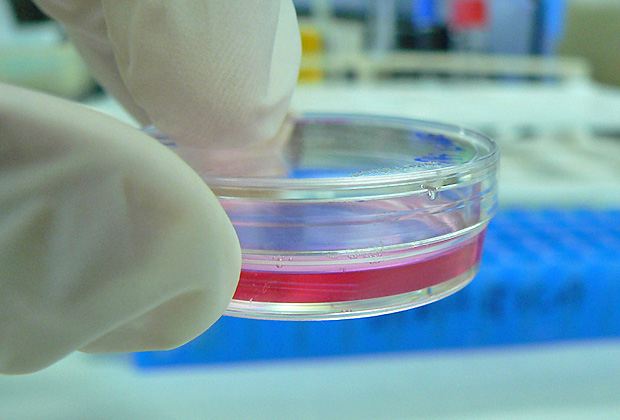

An der 4. Nachhaltigkeitswoche der Zürcher Hochschulen hat der Wissenschaftler Mark Post erklärt, wie er mit dem Züchten von Fleisch in der Petrischale unsere Ernährung und die Umwelt verändern wird. Schon in ein paar Jahren könnte das „Laborfleisch” im Supermarkt erhältlich sein.
Weltweit steigt der Fleischkonsum und ein Rückgang ist nicht in Sicht. Laut der Welternährungsorganisation (FAO) wird die Fleischnachfrage bis 2050 um mehr als 70 Prozent zunehmen. Besonders in Schwellenländern, zum Beispiel in China und Indien, wo sich die Lebensumstände verbessern, möchte man mehr Fleisch essen. Denn je reicher eine Gesellschaft wird, desto mehr Verlangen hat sie nach Fleisch.
Nur noch 35'000 Rinder weltweit?
Das grösser werdende Begehren nach Fleisch kann aber nicht ohne Folgen für das Klima und die Umwelt vonstattengehen. Denn die heutige Fleischproduktion ist nicht nachhaltig. Dem niederländischen Wissenschaftler Mark Post sind besonders die Kühe ein Dorn im Auge. Die Produktion von Rindfleisch ist im Vergleich zu allen anderen Fleischarten am ineffizientesten. Für ein Kilo Rindfleisch benötigt man durchschnittlich acht Kilo Futter. Ausserdem sind Kühe für hohe Treibhausgasemissionen verantwortlich, da sie das starke Treibhausgas Methan ausstossen.
Professor Mark Post forscht seit 2008 an der Universität Maastricht an der Züchtung von Rindfleischzellen. Seine Vision ist es, Fleisch in einem Bioreaktor, einer Art Kühlschrank, zu erzeugen, um das Verlangen der Weltbevölkerung zu stillen und dadurch die negativen Auswirkungen auf die Umwelt um ein Vielfaches zu senken. Dazu würden laut Post nur noch 35'000 Rinder weltweit benötigt werden.
Hamburger für 250'000 Euro
Um Fleisch im Labor herzustellen, brauchen Mark Post und sein Team Muskelzellen, die sie Rindern entnehmen. Diese Zellen vermehren sich anschliessend in einer Petrischale dadurch, dass sie stimuliert werden und unter Spannung stehen. In einer Petrischale sind etwa 5 Millionen Muskelzellen und ein Milliliter Flüssigkeit. Wie beim Menschen, der beim regelmässigen Hanteltraining seinen Bizeps vergrössert, teilen sich die Muskelzellen und verbinden sich langsam zu Muskelfasern. Die gezüchteten Muskelfasern werden abschliessend mittels einer speziellen Technik mit einander verklebt und bilden ein Stück Fleisch.
Die Herstellung des ersten gezüchteten Hackfleischburgers kostete 250'000 Euro. Finanziert wurde er unter anderem vom Google Mitbegründer Sergey Brin. Bisher konnten weltweit nur 15 Menschen das gezüchtete Rindfleisch kosten. 2013 wurde der Hackfleischburger in einer britischen TV-Sendung von Experten probiert. Das Ergebnis war nüchtern: Die Konsistenz sei wie ein richtiger Burger, die Farbe in Ordnung, aber der Geschmack fad und nichts aussagend. Mark Post nahm das zur Kenntnis und begann einen Laborburger mit echtem Geschmack und Farbe zu entwickeln.
Omega 3 und Omega 6 Fettmoleküle
Fett ist bekanntlich Geschmacksträger, deshalb muss dem Fleisch Fett zugeführt werden. Tierische Fette erhöhen aber unter anderem das schlechte Cholesterin im Menschen. Post hat einen Weg gefunden, das Fleisch nicht nur schmackhaft, sondern auch noch gesünder als herkömmliches Fleisch zu machen. Beim Prozess der Fleischbildung wird den Muskelzellen Omega 3 und Omega 6 Fettmoleküle beigegeben. Diese ungesättigten Fettsäuren sind wichtig für eine gesunde Ernährung. Die Omega-Fette werden schliesslich von den Muskelzellen aufgenommen und sorgen beim Verzehr für einen leckeren, echten Geschmack.
Als nächstes sollte auch die Farbe des Laborburgers möglichst natürlich aussehen. Die ersten Versuche mit Lebensmittelfarben aus Rote Beete-Saft und Safran waren für Mark Post nicht befriedigend. Das Fleisch sollte von selbst seine Farbe kriegen. Der Wissenschaftler erkannte, dass die Farbe nur ins Fleisch gelangen könne, wenn es sich so färbt wie bei den Rindern. Die rote Farbe von Fleisch entsteht durch das Protein Myoglobin, welches das Fleisch in Kombination mit Eisen und Sauerstoffmangel rot aussehen lässt. Der gelernte Mediziner Post hat sogleich die Sauerstoffkonzentration in den Züchtungsschränken gesenkt und den Eisengehalt erhöht, schon sieht das heranwachsende Fleisch saftig rot aus.
Konsumenten haben das letzte Wort
Eine letzte Hürde bleibt dem niederländischen Forscher noch. Es muss die Konsumenten von seinem besseren und gesünderen Fleisch überzeugen. Schlagende Argumente wie die nachhaltigere Produktion, das verbesserte Tierwohl, die gesteigerte Qualität und der völlige Verzicht auf Antibiotika könnten die Kritiker umstimmen. Nicht zuletzt wäre es möglich, das Fleisch in der eigenen Küche mittels eines speziellen Züchtungsschranks innerhalb von neun Wochen herzustellen.
Laut Post könnten in den nächsten vier bis fünf Jahren die ersten Laborburger im Handel erhältlich sein. Bis dahin muss die Produktion effizienter gestaltet werden. Derzeit würde ein Kilo Labor-Hackfleisch 66 US-Dollar kosten. Um die Akzeptanz von Laborfleisch in der Bevölkerung zu erhöhen und schliesslich den Verzehr von herkömmlichem Fleisch zu senken, bedarf es nicht zuletzt einer Mentalitätsänderung und damit einhergehend eine veränderte Sichtweise des Fleischverzehrs.